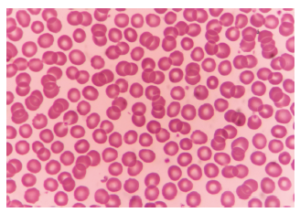
Human red blood cells

IB DP Biology- B2.3 Cell specialization- IB Style Questions For HL Paper 2 -FA 2025
Question
The image shows human red blood cells:
a. Outline what will happen to human red blood cells if transferred to distilled water. [1]
b. State one other condition treated using stem cells. [1]
c. Explain the propagation of nerve impulses along the membrane of a neuron. [3]
▶️ Answer/Explanation
Solution
a. Red Blood Cells in Distilled Water: [1]
• Cells will swell and burst (lyse) due to water entering by osmosis ✔
Mechanism: Distilled water is hypotonic → net water movement into cells
b. Stem Cell Treatments: [1]
• Leukemia (hematopoietic system diseases) ✔
• Skin burns (epidermal regeneration) ✔
• Alternative accepted answers: Spinal cord injuries, Parkinson’s disease, diabetes
c. Nerve Impulse Propagation: [3]
1. Depolarization:
- Na+ channels open at threshold potential (-50mV) ✔
- Na+ influx reverses membrane potential (+30mV) ✔
2. Local currents:
- Ions diffuse laterally between depolarized and polarized regions ✔
- Reduces next segment’s resting potential (-70mV → -50mV) ✔
3. Saltatory conduction (in myelinated neurons):
- Impulse jumps between Nodes of Ranvier ✔
- Faster propagation than unmyelinated axons ✔
Sequence: Resting potential → Threshold → Depolarization → Repolarization → Propagation
